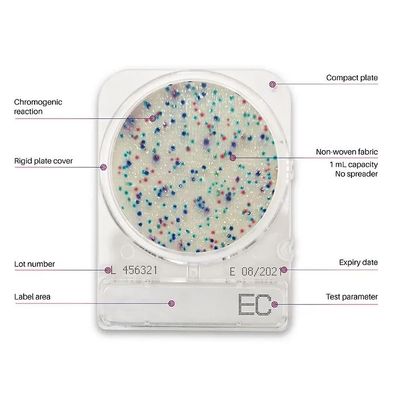

The Tansha products
Food Division - Compact Dry
Compact Dry™ - Microbial Testing Kit
Compact Dry™ is an innovative chromogenic media plate designed for rapid and precise microbial testing. Developed by Nissui Pharmaceuticals Co., Ltd., this ready-to-use plate serves as an efficient alternative to conventional plating methods, saving significant time in microbial assays. It streamlines the workflow by eliminating the need for media preparation and sterilization, making it beneficial for both large manufacturers and small-scale companies. Compact Dry™ supports microbial testing with minimal training, offering tests for a variety of parameters, including spoilage organisms and pathogens. With its self-diffusing media, it requires only a 10-second hands-on time and provides results in as little as 24-48 hours for most parameters. The plate`s innovative design features a robust cover to prevent contamination and a compact form that allows unlimited stacking without compromising microorganism growth.
Food Division - Antibiotic Testing-TABP
TABP - Nitrofurantoin (AHD) ELISA Kit
High sensitivity 0.06-0.24 ppb for different samples. High recovery rate. Fast result in 1 hour
Furaltadone (AMOZ) ELISA Kit
High sensitivity 0.1 ppb for different samples. High recovery rate. Fast result in 2.5 hours.
Pharma Divison - Clean Room Disinfectants
Steri Perox Solution
This is 6% pure hydrogen peroxide , vaccum packed and is one of the best fungicidal and mild sporicide to be utilized directly on your filling lines. This is one disinfectant which evaporates as oxygen leaving behind only W.F.I. which can be easily removed from your filling lines with either 70% IPA cleaning cycle or with a dry wipe from the surface and the best part is that it will not leave any residues on your critical filling lines.
Model DEC-SPORE 200 Plus - Peractic Acid & Hydrogen Peroxide Solution
This is one of the best sporicidal agents to be utilized for once a week for walls , floors and ceilings. It is very strong at 5% formulation and can destroy upto 4 – log in bacteria and upto 3- log with spores in vegetative formats and brings down the overall bioburden of your area. Typically it is utilized in rotation only once a week because of its strong nature it leaves residues behind and it is quite pungent , hence suggest to utilize the same during less man movement to create minimum disturbance.